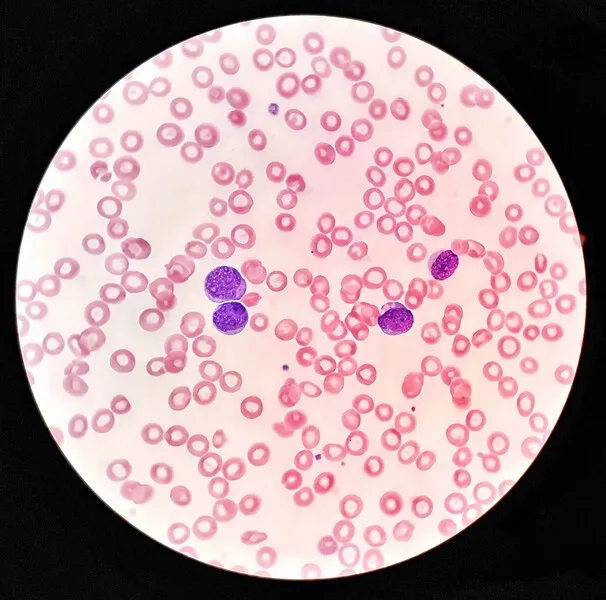
r&oacute;żne rozmiary czerwonych krwinek anizocytoza

Wskaźnik RDW-CV w morfologii krwi to często pomijany, ale niezwykle ważny parametr, który może dostarczyć cennych informacji o stanie Twojego zdrowia. Zrozumienie, czym dokładnie jest RDW-CV i co oznaczają jego wartości, jest kluczowe dla właściwej interpretacji wyników badań, zwłaszcza w kontekście diagnostyki różnych typów niedokrwistości. W tym artykule pomogę Ci rozszyfrować znaczenie tego parametru i wyjaśnię, kiedy warto zwrócić na niego szczególną uwagę.
RDW-CV to wskaźnik zróżnicowania wielkości krwinek co oznacza dla Twojego zdrowia?
- RDW-CV (Red Cell Distribution Width Coefficient of Variation) mierzy zróżnicowanie wielkości czerwonych krwinek (anizocytozę).
- Standardowa norma w Polsce to zazwyczaj 11,5%14,5%, ale zawsze należy sprawdzić zakres referencyjny na swoim wyniku.
- Podwyższone RDW-CV jest częstsze i może wskazywać na niedokrwistość z niedoboru żelaza, witaminy B12 lub kwasu foliowego, a także inne stany.
- Obniżone RDW-CV występuje rzadko i zazwyczaj nie ma istotnej wartości diagnostycznej, jeśli pozostałe parametry są w normie.
- Pełna interpretacja RDW-CV wymaga analizy w połączeniu z innymi wskaźnikami, zwłaszcza MCV.
- Samodzielna interpretacja wyników może być myląca; zawsze należy skonsultować je z lekarzem.
Czym jest RDW-CV i dlaczego warto go rozumieć?
RDW-CV, czyli Red Cell Distribution Width Coefficient of Variation, to wskaźnik, który dostarcza nam informacji o zróżnicowaniu wielkości czerwonych krwinek (erytrocytów) we krwi. Mówiąc prościej, mierzy on, jak bardzo różnią się od siebie rozmiary poszczególnych krwinek. Wynik RDW-CV wyrażany jest w procentach. Im wyższa wartość procentowa, tym większe różnice w wielkości pomiędzy erytrocytami, co jest określane mianem anizocytozy. Z mojej perspektywy, jest to jeden z tych parametrów, który potrafi powiedzieć nam wiele o wczesnych etapach pewnych zaburzeń, zanim jeszcze inne wskaźniki zdążą się zmienić.
Jakie są prawidłowe wartości? Sprawdź normy RDW-CV dla dorosłych
Dla większości laboratoriów w Polsce, standardowa norma RDW-CV dla dorosłych mieści się zazwyczaj w przedziale 11,5%14,5%. Ważne jest jednak, aby zawsze odnosić się do zakresu referencyjnego podanego bezpośrednio na wydruku Twojego wyniku badania. Normy te mogą się nieznacznie różnić w zależności od aparatury analitycznej używanej przez dane laboratorium. Zawsze podkreślam moim pacjentom, że to właśnie te indywidualne normy są najważniejsze.
Kiedy wynik RDW-CV jest uznawany za prawidłowy?
Wynik RDW-CV mieści się w normie, gdy jego wartość procentowa znajduje się w zakresie referencyjnym podanym przez laboratorium. Oznacza to, że Twoje czerwone krwinki są stosunkowo jednorodne pod względem wielkości. Taka jednorodność jest zazwyczaj dobrym sygnałem i świadczy o prawidłowym procesie produkcji erytrocytów w szpiku kostnym.
Podwyższone RDW-CV: czy to zawsze powód do niepokoju?
Podwyższone RDW-CV to zjawisko znacznie częstsze niż obniżony poziom tego wskaźnika i często budzi pytania u pacjentów. Wysoki wynik wskazuje na anizocytozę, czyli obecność we krwi czerwonych krwinek o zróżnicowanej wielkości. Wiele osób zastanawia się, czy to od razu powód do paniki. Moje doświadczenie pokazuje, że choć zawsze wymaga to uwagi, to nie zawsze oznacza poważną chorobę, ale z pewnością jest sygnałem do dalszej diagnostyki.
Anizocytoza, czyli co się dzieje, gdy krwinki czerwone różnią się wielkością
Anizocytoza to termin medyczny opisujący stan, w którym we krwi występują krwinki czerwone o znacznie różniących się rozmiarach. Zamiast mieć w miarę jednolitą wielkość, obserwujemy zarówno mniejsze, jak i większe erytrocyty. To zróżnicowanie jest kluczowym sygnałem diagnostycznym, ponieważ wskazuje na zaburzenia w procesie erytropoezy, czyli tworzenia czerwonych krwinek w szpiku kostnym. Organizm może produkować krwinki o nieprawidłowych rozmiarach z różnych powodów, co właśnie odzwierciedla wysokie RDW-CV.
Najczęstsza przyczyna wysokiego RDW-CV: niedokrwistość z niedoboru żelaza
Z mojej praktyki wynika, że najczęstszą przyczyną podwyższonego RDW-CV jest niedokrwistość z niedoboru żelaza. Kiedy organizmowi brakuje żelaza, niezbędnego do produkcji hemoglobiny, szpik kostny zaczyna wytwarzać krwinki czerwone o różnej wielkości często mniejsze i bledsze. Co ciekawe, wysokie RDW-CV może być jednym z pierwszych sygnałów tego niedoboru, pojawiającym się niekiedy wcześniej niż zmiany w poziomie hemoglobiny czy średniej objętości krwinki (MCV). Dlatego tak ważne jest, aby nie lekceważyć tego parametru.
Inne możliwe powody podwyższonego wyniku: od niedoborów witamin po choroby wątroby
Choć niedobór żelaza jest głównym podejrzanym, podwyższone RDW-CV może mieć również inne przyczyny. Wśród nich warto wymienić:
- Niedobory witaminy B12 lub kwasu foliowego, które są kluczowe dla prawidłowego dojrzewania erytrocytów.
- Stan po transfuzji krwi, gdzie we krwi pacjenta pojawiają się krwinki dawcy, różniące się od jego własnych.
- Ostre lub przewlekłe krwotoki, które prowadzą do zwiększonej, często chaotycznej produkcji nowych krwinek.
- Niektóre choroby wątroby, wpływające na metabolizm i produkcję składników krwi.
- Zespoły mielodysplastyczne, czyli zaburzenia szpiku kostnego, które prowadzą do wytwarzania nieprawidłowych komórek krwi.
Jakie objawy mogą towarzyszyć podwyższonemu RDW-CV?
Objawy towarzyszące podwyższonemu RDW-CV są ściśle związane z jego przyczyną, najczęściej z niedokrwistością. Pacjenci mogą doświadczać:
- Przewlekłego zmęczenia i osłabienia, nawet po odpoczynku.
- Bladości skóry i błon śluzowych.
- Duszności, zwłaszcza podczas wysiłku.
- Zawrotów głowy i problemów z koncentracją.
- Kołatania serca.
Warto pamiętać, że objawy te mogą być subtelne i narastać stopniowo, dlatego często są początkowo bagatelizowane.
Obniżone RDW-CV: co oznacza wynik poniżej normy?
Obniżone RDW-CV to znacznie rzadsze zjawisko niż podwyższony poziom tego wskaźnika. Zazwyczaj, kiedy widzę taki wynik, nie budzi on u mnie tak dużego niepokoju, jak wysokie RDW-CV, ponieważ jego wartość diagnostyczna jest często ograniczona.
Dlaczego niskie RDW-CV występuje znacznie rzadziej?
Niskie RDW-CV oznacza, że czerwone krwinki są bardzo jednorodne pod względem wielkości. Choć może to wydawać się pozytywne, w kontekście diagnostyki ma mniejsze znaczenie. Obniżone RDW-CV może pojawić się w przypadku anemii aplastycznej, gdzie produkcja krwinek jest znacznie zmniejszona, a te, które są produkowane, mogą być jednorodne. Może również towarzyszyć niektórym rodzajom niedokrwistości przewlekłych, na przykład związanych z chorobami nerek. Jednakże, jak już wspomniałem, jego ograniczona wartość diagnostyczna sprawia, że rzadko jest to jedyny parametr, na którym opieramy diagnozę.
Czy niska wartość RDW-CV przy prawidłowej morfologii to sygnał alarmowy?
Zazwyczaj, jeśli niski wynik RDW-CV jest jedynym odchyleniem od normy w morfologii krwi, a pozostałe parametry są prawidłowe, nie jest to powód do niepokoju. W takich sytuacjach często nie wymaga to dalszej diagnostyki, ponieważ nie wskazuje na żadne istotne zaburzenia w produkcji czy funkcjonowaniu czerwonych krwinek. To jeden z tych przypadków, kiedy "za niska" wartość jest mniej problematyczna niż "za wysoka".

Klucz do interpretacji: jak analizować RDW-CV razem z MCV?
Pojedynczy wynik RDW-CV daje nam pewne wskazówki, ale prawdziwy klucz do interpretacji leży w analizie tego wskaźnika razem z MCV (średnia objętość erytrocytu). Ta kombinacja jest absolutnie fundamentalna dla wstępnego różnicowania rodzajów niedokrwistości. Jako lekarz, zawsze patrzę na te dwa parametry razem, ponieważ ich wzajemne relacje pozwalają znacznie zawęzić pole diagnostyczne.
Jakie kombinacje RDW-CV i MCV wskazują na konkretne stany?
Poniższa tabela przedstawia najczęstsze kombinacje wyników RDW-CV i MCV oraz ich możliwe znaczenie diagnostyczne:
| Kombinacja RDW-CV i MCV | Możliwe znaczenie diagnostyczne |
|---|---|
| Wysokie RDW-CV + Niskie MCV | Sugeruje anemię z niedoboru żelaza (często wczesna faza). |
| Wysokie RDW-CV + Wysokie MCV | Może wskazywać na anemię z niedoboru witaminy B12 lub kwasu foliowego. |
| Wysokie RDW-CV + Normalne MCV | Może być wczesnym sygnałem anemii z niedoboru żelaza lub witaminy B12/kwasu foliowego. |
| Normalne RDW-CV + Niskie MCV | Może sugerować anemię w chorobach przewlekłych lub talasemię. |
Otrzymałeś wynik badania? Oto co robić dalej
Otrzymanie wyników badań krwi zawsze budzi pewne emocje i pytania. Niezależnie od tego, czy RDW-CV jest w normie, czy wykazuje odchylenia, najważniejsze jest, aby pamiętać o kolejnych krokach. Samodzielna interpretacja może być kusząca, ale z mojej perspektywy, profesjonalna konsultacja jest niezastąpiona.
Dlaczego samodzielna interpretacja wyników może być myląca?
Samodzielna interpretacja wyników morfologii krwi, w tym RDW-CV, jest niewskazana i może prowadzić do błędnych wniosków. Diagnostyka medyczna to złożony proces, który wymaga uwzględnienia nie tylko pojedynczych parametrów, ale całego obrazu klinicznego pacjenta jego objawów, historii medycznej, innych chorób współistniejących oraz wyników wszystkich badań. Pojedynczy parametr, nawet tak informacyjny jak RDW-CV, rzadko daje pełną odpowiedź na pytanie o stan zdrowia. Często widzę, jak pacjenci zbyt szybko wyciągają wnioski na podstawie fragmentarycznych danych, co prowadzi do niepotrzebnego stresu lub zaniechania dalszych, koniecznych działań.
Rola lekarza w analizie morfologii: kiedy umówić się na konsultację?
Kluczową rolę w prawidłowej interpretacji wyników RDW-CV i całej morfologii krwi odgrywa lekarz. Tylko on jest w stanie ocenić wyniki w kontekście Twojej indywidualnej sytuacji zdrowotnej. Dlatego też, każda nieprawidłowość w wynikach powinna być skonsultowana z lekarzem niezależnie od tego, czy jest to podwyższone, czy obniżone RDW-CV. Lekarz zadecyduje, czy konieczne są dalsze badania, czy też wynik mieści się w granicach, które nie wymagają interwencji.
Przeczytaj również: Gdzie zrobić CV? Porównanie kreatorów i sekrety skutecznego życiorysu
Badania do pracy a wynik RDW-CV: jak to wpływa na orzeczenie lekarskie?
Morfologia krwi, w tym wskaźnik RDW-CV, jest standardowym badaniem wykonywanym w ramach medycyny pracy. Służy ono ocenie ogólnego stanu zdrowia pracownika i jego zdolności do wykonywania określonych obowiązków. Odchylenia od normy w RDW-CV mogą wymagać dalszej diagnostyki, aby wykluczyć poważniejsze schorzenia. Jednakże, rzadko stanowią one samodzielną podstawę do wydania negatywnego orzeczenia o zdolności do pracy. Zwykle dzieje się tak tylko wtedy, gdy wskazują na poważną, nieleczoną chorobę, która bezpośrednio wpływa na bezpieczeństwo pracy lub zdrowie pracownika. W większości przypadków, lekarz medycyny pracy może zalecić konsultację z lekarzem rodzinnym lub specjalistą w celu wyjaśnienia nieprawidłowości, zanim podejmie ostateczną decyzję.
